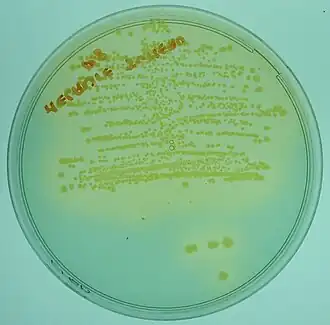

Isolement (microbiologie)
.jpg)
L'isolement est une technique qui permet de séparer les microorganismes (bactéries ou champignons) d'un échantillon en réalisant un étalement sur des milieux de culture solides, sélectifs ou non, pour les différencier. L'isolement permet d'obtenir des colonies différentes, espacées les unes des autres. On cherche à isoler les différentes cellules de l'échantillon, chaque cellule isolée étant alors potentiellement susceptible de conduire à une colonie (mais parfois on obtiendra des colonies mixtes difficilement résolubles ...).
Isolement par la méthode des quadrants

La méthode des quadrants[1] consiste à diviser une boîte de Petri en deux (50 % et 50 %), puis de diviser de nouveau par deux une moitié afin d'obtenir 3 quadrants de 50 %, 25 % et 25 %. Sur le plus grand quadrant une petite quantité d'inoculum est posée puis étalée[2]. La boîte est ensuite tournée d'un quart afin d'étaler en stries serrées les bactéries à l'aide d'une pipette Pasteur boulée, d'une anse de platine ou d'une anse plastique jetable, sur un quadrant plus petit, puis de nouveau tournée d'un quart afin d'ensemencer le dernier petit quadrant. L'instrument utilisé (sauf s'il est en plastique) peut éventuellement être flambé entre chaque quadrant pour de meilleurs résultats. Il ne faut pas passer deux fois au même endroit et de ne pas revenir "en arrière" lorsque l'on fait pivoter la boîte, sinon l'anse (ou la pipette) risque de se surcharger et l'isolement sera moins réussi. C'est sur le dernier quadrant que se retrouvent les colonies isolées[2]. C'est l'expérience qui permettra de déterminer la technique la plus adaptée à l'opérateur car de nombreuses variantes sont possibles. Le chauffage de l'instrument n'est pas conseillé car le risque est de tuer certains microorganismes et que l'attente du refroidissement est une perte de temps.
Une autre méthode : les microorganismes à la périphérie de la boîte de Petri sont déposés, puis on les étale vers le centre de la boîte. Il est important de ne pas aller trop loin dans la périphérie lors du balayage du centre. Cette méthode demande plus de technique que la première[3].
Cas des urines : isolement avec dénombrement (numération)
Dans le cas des urines, l'utilisation d'une anse calibrée jetable de 10 µL assure un dépôt normalisé. Une strie droite est réalisée jusqu'au milieu de la boite puis des stries horizontales perpendiculaires sur l'ensemble de la boite.
En lien avec une abaque, une évaluation de la concentration microbienne est faite.
Cette méthode est notamment utilisée dans le cas des prélèvements d'urine[2] et permet une évaluation de la concentration microbienne à condition d'utiliser une anse calibrée (10 µL) pour le dépôt de l'inoculum. Le milieu utilisé peut-être CLED ou des milieux chromogènes.

Lecture de l'isolement
Une fois l'isolement effectué et incubé, des colonies bactériennes apparaissent; elles sont d'aspect M, R ou S[4]. Outre la macroscopique, les variations de couleur du milieu ou des colonies permettent de déterminer des caractères biochimiques des microorganismes des colonies.
R pour Rugueuses
Les colonies de type R (pour Rough en anglais) ne sont pas rondes, les bords sont hachurés, irréguliers, et des cavités sont visibles à la surface de la colonie[4],[5].
S pour Smooth
Les colonies de type S (pour smooth en anglais) ont des bords réguliers, semi-bombés, une surface lisse et a consistance crémeuse et en suspension elles sont homogènes[4],[5].
M pour Muqueuse
Les colonies M (pour mucous en anglais) sont d'un aspect brillant et collant (comme le miel), mucoïde[4],[5]. Le fait qu’elles soient collantes est dû à la sécrétion d’exopolysaccharides par les bactéries. Elles s'étirent lors d'un prélèvement. L'aspect gras est dû à leur capsule.
Références
- ↑ Ayoub Bensakhria, « Milieux de culture et Techniques d’ensemencement », sur Magazine Science,
- 1 2 3 Lanotte, Isnard et et al. 2016, p. 28.
- ↑ Lanotte, Isnard et et al. 2016, p. 29.
- 1 2 3 4 Rullier et Parodi 1968, p. 376.
- 1 2 3 Hauduroy 1947, p. 51.
Bibliographie
- Philippe Lanotte, Christophe Isnard, F. Garnier et L. Mereghetti (ill. Carole Fumat), « Chapitre 3. Du prélèvement à la caractérisation des souches. 3.1. Démarche de l'examen bactériologique. Culture et isolement des bactéries », dans Bactériologie médicale : techniques usuelles, Issy-les-Moulineaux, Elsevier Masson (François Denis, Marie-Cécile Ploy, Christian Martin et Vincent Cattoir), , 3e éd., 575 p. (ISBN 9782294746161).
- Jean Rullier et A. Parodi, Laboratoire et diagnostic en médecine vétérinaire, Vigot, , 712 p., « Identification par isolement et culture »
- Paul Haudruroy, Microbiologie générale et technique microbiologique, Masson, , 622 p., « Les colonies microbiennes »
- Joffin Jean-Noël, Leyral Guy, Dictionnaire des Techniques de Microbiologie, Lexitis, 2015, nouvelle édition, 418 p., (ISBN 978-2-36233-196-1)
- Portail de la microbiologie